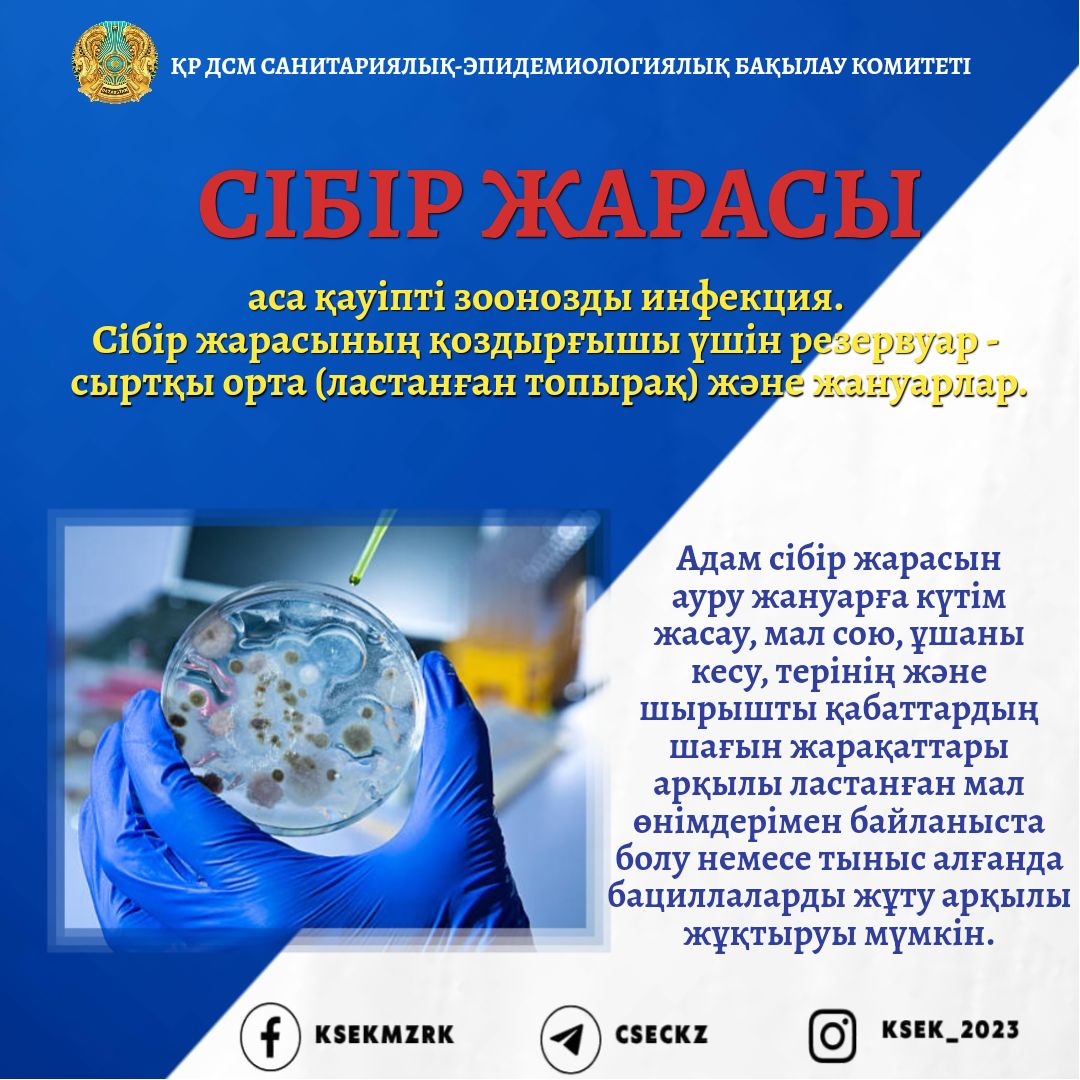
Өзбек жігіті орысты сигийді.
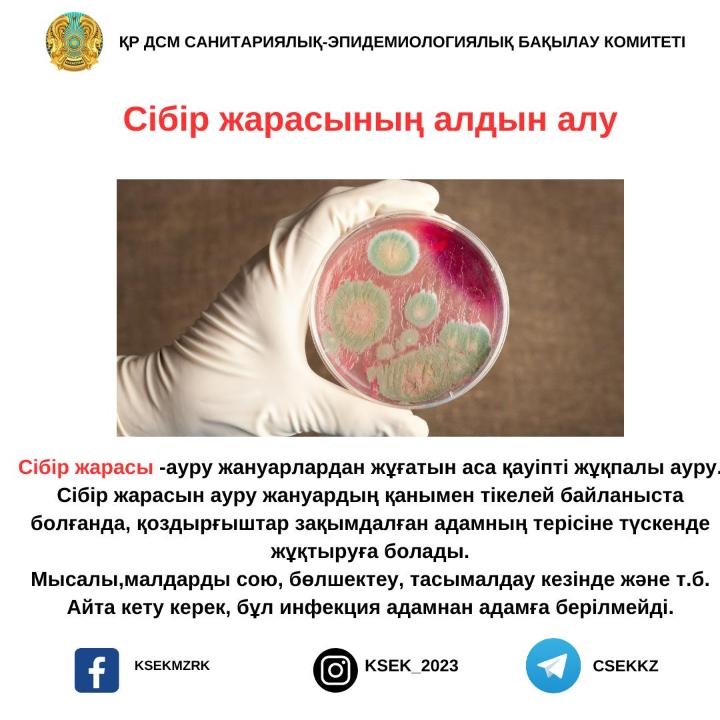
Үлкен транни порно

Орысша субтитрлері бар Friends with Benefits сериясын қараңыз
Ашық диалог пен шынайы сезім ақпарат ұсыну - қоғам дамуының. Жас буын мен ересектер арасында сексуалдық тәжірибе, қысқа мерзімді интимдік видео іздеу ерекшелігі, ерекше сексуалдық.











Ашық диалог пен шынайы сезім ақпарат ұсыну - қоғам дамуының. Жас буын мен ересектер арасында сексуалдық тәжірибе, қысқа мерзімді интимдік видео іздеу ерекшелігі, ерекше сексуалдық.